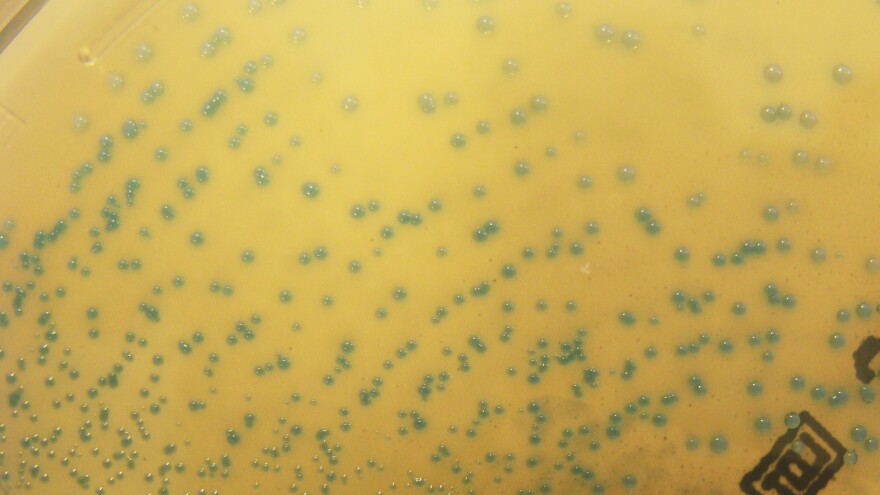
Streptococcus colony

Author Isaac Asimov once wrote, "The most exciting phrase to hear in science, the one that heralds new discoveries, is not 'Eureka!' but, 'That's funny ... ' "
Good scientists search for the significance of surprises, coincidences and mistakes. With a little curiosity and perseverance, they can turn unexpected incidents into new insights.
The Golden Mole Award, from NPR's Skunk Bear, celebrates these moments of serendipity in science. We asked for examples of happy accidents in the lab and in the field from the past few years ... and 300 submissions came pouring in.
Here are a few of our favorite stories — a shortlist of Golden Mole Award nominees.

1. WHEN FROGS ATTACK
Carlos Jared was doing fieldwork in the jungles of southwest Brazil when he picked up a harmless-looking frog. The frog twisted and thrashed, butting Jared's hand with his head. Excruciating pain spread up Jared's arm, and for the next five hours he was in agony.
He had inadvertently discovered that frogs can be venomous.
Many amphibians secrete toxins through their skin, but the frog Jared picked up — Greening's frog — was the first discovered to actually force those toxins into a predator's bloodstream. When attacked, it retracts the skin around its upper lip, revealing bony spines. Jared and collaborator Edmund Brodie discovered that a gland at the base of each spine produces a toxic mucus that is twice as potent as the venom of a Brazilian pit viper.

2. A LIGHT BULB MOMENT
Engineer David Awschalom had just moved from the University of California, Santa Barbara to the University of Chicago when his research hit a snag. His team was investigating a strange material that they hoped could someday be used in quantum computing — a thin sheet of atoms on a bed of strontium titanate.
But their experimental results were full of incomprehensible noise. It took months for graduate students Andrew Yeats and Peter Mintun to isolate the problem: the lab's new energy-efficient light bulbs, installed per university policy.
The bulbs happened to emit the exact wavelength of light that could polarize the strontium titanate and influence their new material's electrical properties. With a little tweaking, they were able to use this wavelength to gently and rapidly "paint" electrical junctions on the fragile material. Shine light of a second specific wavelength, and the circuits were erased. What amounts to an optical Etch A Sketch could someday help scientists build quantum computers.

3. OUT OF THE BLUE
Blue is a notoriously tricky pigment. It's rare in nature — the stone originally used to produce blue paint was once worth more than gold. So humans tried to manufacture the blues they needed ... with mixed results. The dyes and paints they came up with often turned out to be poisonous, expensive, impermanent — or all three.
Mas Subramanian wasn't at all interested in this problem. In the department of chemistry at Oregon State University, he was looking for materials with novel magnetic properties to use in advanced computer hard drives. He would mix up likely chemicals and bake them in a furnace at 2,000 degrees Farenheit. But when he added manganese oxide to the recipe, he got a colorful surprise — a pile of bright blue powder.
The new pigment is stable and nontoxic. It reflects infrared radiation, so it might help keep buildings and vehicles cool. Subramanian is working with paint manufacturers and energy conservation companies to develop the product.

4. BEATING THE HEAT
Climate change poses a major threat to pikas, adorable little mammals that live mostly in the mountains of the American West. They can overheat in temperatures as low as 75 degrees Fahrenheit. Most make their dens at higher elevations, in rock slides where they can stay cool.
But one population in Oregon's Columbia Gorge thrives near sea level. Ecologist Johanna Varner wanted to find out why. She spent months watching pikas and deploying heat sensors at this low-elevation site. For reference, she did the same at a more typical site, along the slopes of nearby Mount Hood.
Days after her first summer in the field ended, a fire consumed the Mount Hood site, burning trees to the ground and destroying all the food stores of the pikas. The experiment she had planned was ruined — her mountainside "control" site was clearly no longer controlled.
But after some tears and a couple of cold beers, Varner realized the disaster was an opportunity. First, there were the data collected by her heat sensors during the fire. The temperature in the pika dens, she discovered, never rose above 75 degrees F, even when 900-degree fires were raging just feet away. Secondly, her summer spent surveying the pika population formed a rare reference point for the study of a species' recovery after the fire.

5. THE DANCE OF THE DROPLETS
As an undergrad, Nate Cira was looking at food coloring under a microscope when he noticed something odd. Two drops of different colors seemed to dance around each other, almost as if they were alive.
When Cira started graduate school at Stanford University, he showed the oddity to his adviser, Manu Prakash. Both men became obsessed with the phenomenon. They spent three years trying to figure out what was causing the strange motion.
It turns out the dynamic dance was the result of two simple physical phenomena: surface tension and evaporation. The vapor given off by one droplet acted like a signal to the other — they were, in a sense, communicating. The principles Prakash, Cira and their collaborator Adrien Benusiglio uncovered could be used to create autonomic liquid machines, such as self-cleaning solar panels.

6. A CASE OF MISTAKEN GENITALIA
Melissa Brown was at Northwestern University studying mice with multiple sclerosis. Like most MS researchers, Brown exclusively used female mice — the males just don't get sick.
She was embarking on a set of experiments using mice with a genetic mutation that hobbles their immune system. Normal female mice get very sick. Female mice with the mutation seem to do better. Brown wanted to find out why.
But when the results came in, some of them were the opposite of what was expected. Some of the normal mice were healthy. Some of the mice with the mutation were getting sick. A closer inspection of the test subjects revealed why. The mice with the surprising results were male! A graduate student on the project, Margaret Caulfield, was new to the lab and hadn't yet learned to identify the nearly imperceptible genitals of male mouse pups.
The mix-up turned out to be a lucky one. It helped Brown, Caulfield and graduate student Abby Russi pinpoint a special group of cells that protect male mice from MS — innate lymphoid cells. The discovery opens new doors for MS researchers.

7. THE SECRET IN THE SERUM
A disease called myelofibrosis causes scar tissue to grow inside bone marrow. It all starts when white blood cells called monocytes enter the marrow and turn into fibrocytes. For years, scientists have searched for a way to stop fibrocyte formation. The only problem? The process was impossible to study. Under normal lab conditions, when monocytes are grown in blood serum, the transformation just doesn't happen. No fibrocytes.
Darrell Pilling and Richard Gomer, biologists at Texas A&M, were recently investigating an entirely different kind of blood cell. They wanted to find out if T cells could survive in a serum-free culture. Unbeknownst to the researchers, their T-cell samples were contaminated with monocytes. And when they looked at their culture under a microscope, they saw ... fibrocytes.
Something in the serum had been keeping the monocytes from transforming.
Pilling and Gomer rapidly changed gears, abandoning their work on T cells and focusing on the monocytes instead. They managed to isolate the serum protein that stopped fibrocyte formation. It is now being tested as a treatment for myelofibrosis.

8. WASPS, FACE TO FACE
As a young graduate student, Liz Tibbetts was studying social hierarchy in wasp colonies. She caught the wasps and painted dots on their backs, so she could tell them apart, and then videotaped their behavior.
Tibbetts failed to mark a few of the wasps and didn't realize her mistake until she was reviewing the video. It was a problem. If she couldn't follow individuals, she couldn't get the data she needed. But, looking a bit closer, she realized she could tell the wasps apart without the paint. The face of each insect had distinct colors and shapes.
Tibbetts wondered if the wasps could also recognize each other. To an experienced researcher this might have seemed outlandish — prevailing wisdom held that social insects couldn't distinguish between individuals. But Tibbetts was new to the field, and so she asked the question anyway.
Her research showed that not only can wasps tell each other apart, but their tiny brains have evolved in a way that allows them to particularly recognize faces. This ability allows for complex social interactions within colonies.
9. A COLORFUL DEFENSE
Bacteria can be wildly colorful, blooming in bright red and yellow colonies. But researchers studying bacterial disease usually aren't focused on aesthetics.
George Liu, working at the University of California, San Diego, was no exception. He was looking at two varieties of Streptococcus — a normal strain and a mutant strain that couldn't produce a nasty toxin. (The mutant also couldn't produce pigment, but that didn't seem important.)
Liu's experiments were going terribly, full of inconsistent results. Sometimes the bacteria inexplicably died off. Then Liu caught a whiff of bleach in his glassware. An enthusiastic undergraduate had been using bleach to clean the lab's beakers and flasks, and hadn't rinsed them properly. Reviewing his results, Liu noticed that the normal strain of bacteria survived the bleach more often than the mutant strain. But why? Was the toxin somehow protective against bleach?
A second realization came when Liu's mother was nagging him about eating brightly colored vegetables. He remembered that many pigments have antioxidant properties. Maybe it was the pigment, and not the toxin, that was somehow protecting the bacteria.
But why would Streptococcus evolve to produce pigment? It wouldn't be common for the bacteria to encounter cleaning products when they invaded bodies. The final flash of insight came when Liu read the back of the bleach bottle. The fancy chemical name for bleach's active ingredient is hypochlorite — one of the chemicals released by immune cells when they attack bacterial infections.
Further experiments confirmed his hypothesis — Streptococcus was using pigment to neutralize the immune system's hypochlorite. Liu had stumbled upon one of strep's secret weapons.

10. A LITERAL CASE OF ACCIDENTAL BRILLIANCE
Calden Carroll thought that his days as a chemistry graduate student at the University of Oregon were nearly done — his thesis was nearly complete. He believed he had created a molecule that would light up in the presence of chloride. Such a molecule would be useful to scientists studying cystic fibrosis, a disease that disrupts the movement of chloride across cell membranes.
But when he tested his magic molecule, it failed spectacularly. Instead of highlighting chloride, it lit up whenever nitrate was present.
A professor pointed out this failed marker could actually be really useful — not for medicine, perhaps, but for agriculture. Carroll patented his discovery and now has a company that builds nitrate sensors to help farmers fertilize their fields more efficiently.

11. VIRUSES IN GLASS HOUSES
Ken Stedman was searching for fossilized viruses — strains that might have become trapped in the mineral deposits of hot springs millions of years ago.
Would these fossils survive in some recognizable form? To find out, Stedman made an artificial hot spring in his lab and filled it with modern viruses. Sure enough, the viruses quickly became coated with silica. But the results just looked like rocky blobs — there were no signs of the viruses, and no clues that could help him find fossils in the field.
Stedman and a graduate student, Jim Laidler, wanted something to come out of their failed experiment, so they tested to see if the silica-encrusted viruses could still reproduce. They couldn't — the microbes were effectively dead.
Then, a student accidentally left a solution of coated viruses out on the counter when he went home for the evening. Overnight, the silica re-dissolved. The next morning, the viruses were working again.
Further research showed the silica coating didn't only inactivate viruses in a reversible way; it also protected them from drying out and dying in the heat. This technique might someday help deploy a very special group of viruses — the sort used in vaccines — in places that lack ready refrigeration.

12. LOVE BUG
Shelley Adamo was a biologist at Dalhousie University studying crickets — specifically, how they respond to stress. How do you stress out a cricket? Introduce it to a predator.
One of Adamo's students had pet bearded dragons, and she brought them in to scare the crickets. One of the lizards had a virus that quickly infected the crickets. But it didn't make them sick, at least not at first. It made them very, very interested in mating.
She had discovered what she calls a parasitic aphrodisiac — a virus that boosts an animal's libido, thereby increasing its own transmission.
For more science fun, check out Skunk Bear's Tumblr and YouTube channel.
Copyright 2023 NPR. To see more, visit https://www.npr.org.